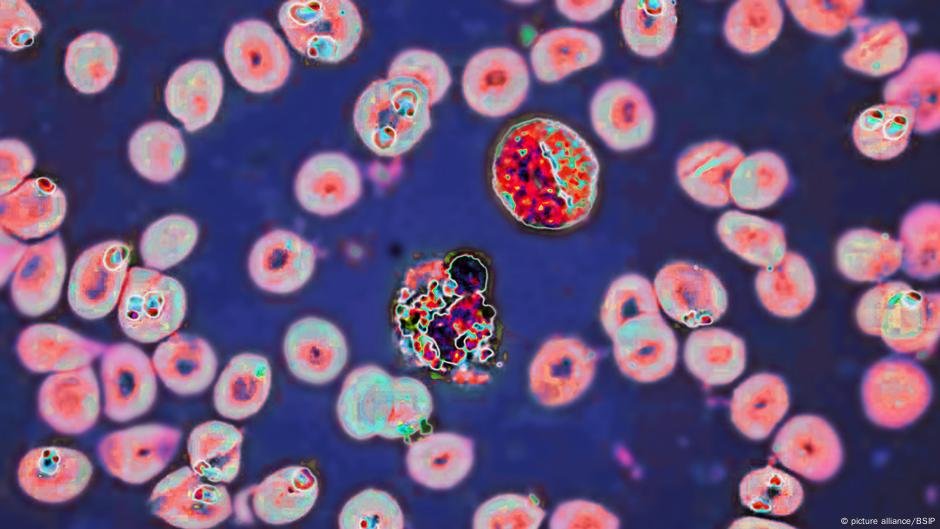
O que sabemos - DW - 03/03/2025

Outro surto de doença misteriosa no República Democrática do Congo surgiu, resultando em pelo menos 60 mortes, dizem as autoridades de saúde.
Segue -se a Evento semelhante em setembro de 2024referido como “doença x” antes do Organização Mundial da Saúde (OMS) identificou -o como um coquetel de várias doenças respiratórias agudas conhecidas complicadas pela malária e desnutrição.
Esses novos surtos podem ter origens semelhantes, mas provavelmente levará tempo para determinar exatamente qual é a causa.
A contaminação tóxica também é considerada uma causa possível.
Qual é a situação atual no Dr. Congo?
Mais de 1.000 casos foram relatados em toda a província equatória do Dr. Congo e 141 casos de um doença foram relatados na zona de saúde de Basankusu. Um surto separado no início de fevereiro consistiu em 158 casos e 58 mortes.
Em janeiro, a vila de Bolamba registrou 12 casos e oito mortes.
O que mostram testes iniciais?
As autoridades de saúde do Dr. Congo e OMS especialistas estão realizando investigações para determinar a causa da doença e das mortes.
Testes de laboratório iniciais descartaram Ebola e Doença de Marburg. Metade desses testados testou positivo para malária.
“Não estamos realmente satisfeitos com a amostragem, então enviamos dois que epidemiologistas lá em cima”, disse Margaret Harris, porta -voz da OMS, ao DW News.
“Eles estão lá em cima agora e estão supervisionando a amostragem e levando -os de volta aos laboratórios na (capital do Dr. Congo) Kinshasa”.
Estão sendo realizados testes adicionais para meningite e potencial contaminação tóxica.
O diretor de emergências da OMS, Mike Ryan, juntamente com as autoridades de saúde locais, favorecem o último como causa.
“Parece que temos algum tipo de evento de envenenamento”, disse Ryan a repórteres.
Montando temores do Dr. Congo Breakup
Para visualizar este vídeo, ative JavaScript e considere atualizar para um navegador da web que Suporta o vídeo HTML5
As autoridades conhecem a fonte do surto?
A causa da doença – e se as doenças em diferentes regiões estão conectadas – permanece desconhecida.
Os primeiros relatórios sugeriram que os primeiros casos estavam entre um grupo de crianças que podem ter comido um bastão, embora esse incidente ainda não tenha sido confirmado como a causa do surto.
Morcegos são reservatórios conhecidos de vírus e outros patógenos causadores de doenças. O Global Health Advice recomenda que as pessoas evitem a exposição a animais mortos.
Embora as principais aldeias de Basankusu e Bolomba sejam de 116 milhas (186 quilômetros), não está claro se os surtos de doença compartilham a mesma causa.
Quais são os sintomas da doença misteriosa?
O memorando mais recente da OMS diz que os sintomas são largos e incluem febre, dores de cabeça, calafrios, sudorese, rigidez no pescoço, dores musculares, dor nas articulações e corporais, tosse, vômito e diarréia.
A amplitude desses sintomas e seu potencial de aplicar a muitas doenças tornam impossível identificar a causa sem análise de amostras biológicas de pacientes.
Alguns especialistas em saúde acreditam que a doença misteriosa provavelmente é causada por vários patógenos conhecidos agindo juntos.
O fato de a malária ter sido encontrada em um em cada dois casos já é uma informação importante para as autoridades de saúde, mas a adição de amostragem e análise adicionais de quem funcionários em conjunto com as equipes locais ajudará a restringir a busca por uma causa.
“Os testes nunca são 100% precisos e é provável que, com o aumento dos testes, tenhamos um patógeno confirmado em algumas dessas amostras”, disse Michael Head, epidemiologista da Universidade de Southampton, Reino Unido.
Quem endossa a vacina da nova malária para o lançamento da África
Para visualizar este vídeo, ative JavaScript e considere atualizar para um navegador da web que Suporta o vídeo HTML5
A doença poderia se espalhar ainda mais?
A infraestrutura de saúde nessa região do Dr. Congo é limitada e há preocupações de que a doença possa se espalhar. Assim como as infecções respiratórias da malária que causaram o surto de 2024, a desnutrição e outras condições subjacentes podem aumentar as chances de morte.
As autoridades de saúde locais estão abordando o MPOX e Surtos de ebola Nos últimos anos, a Head sugere que os desafios de infraestrutura limitada para gerenciar novas doenças podem ser compensados por sua “experiência em lidar com epidemias de doenças infecciosas”.
Se um patógeno anteriormente desconhecido for identificado como a causa, as autoridades de saúde precisarão aumentar as medidas para conter a propagação da doença e identificar o método de transmissão.
Editado por: Fred Schwaller
Esta história foi atualizada.